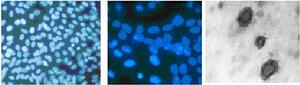
未污染的細胞、支原體污染細胞、電鏡檢測

簡介
支原體是一種大小僅為0.2~0.3 um,無細胞壁,可透過一般過濾膜(0.22-0.45 um)的原核生物,在細胞培養過程中,支原體感染髮生率達到63%,因而細胞培養過程中被支原體污染是一個世界性的難題。當細胞(特別是傳代細胞)被支原體污染後,細胞內的DNA、RNA及蛋白表達發生改變,而細胞的生長率一般並未發生顯著的影響,因而細胞被支原體污染一般難以察覺。
支原體污染檢測方法
一般根據支原體種類不同,採取不同的方法進行檢測。目前常用的檢測方法有:
1. 試劑盒檢測法:
目前已有專門做支原體檢測的試劑盒,可以用細胞滴片進行檢測。
2. 觀察細胞的形態和生長特徵:
支原體污染比較嚴重時可出現生長減慢,有的培養基pH明顯變酸,並出現細胞病變,以此可依次對支原體污染進行檢測,但有些情況下支原體污染引起的病變特徵與病毒感染相似,因此不能準確診斷。
3. 分離培養法:
大多數支原體可出現特有的典型菌落。因而可依次盡心檢測,該方法準確、可靠,但時間長,敏感性不夠高。
4. DNA結合螢光素染色法:
利用螢光染劑(bisbenzimide,Hoechst 33258)偵測支原體污染。螢光染料會結合到DNA之Adenosine-Thymidine (A-T) rich區域,因為支原體DNA中A-T含量占多數(55~80%),所以可將其染色而偵測。被支原體污染之細胞經染色後,在細胞核外與細胞周圍可看到許多大小均一之螢光小點,即為支原體之DNA,證明有支原體之污染。
5. 電子顯微鏡和免疫電子顯微鏡法:電子顯微鏡或者免疫電鏡下對樣本進行觀察,此法較準確,但受條件限制,時間長,敏感性不高。
6. 間接免疫螢光法和免疫印跡:簡便、快速、特異性強。
未污染的細胞、支原體污染細胞、電鏡檢測
未污染的細胞、支原體污染細胞、電鏡檢測支原體污染預防及處理
組織細胞培養工作中,可以從以下幾方面來預防支原體的污染:
控制環境污染;嚴格實驗操作;細胞培養基和器材要保證無菌;在細胞培養基中加入適量的抗生素。
當細胞被支原體污染後若由於材料的特殊性必須保留可以採用一定的抗生素進行處理,對支原體最有抑制活性抗生素是四環素類、大環內酯類等。目前,市場上已有了新一代支原體抗生素M-Plasmocin,能有效的殺滅支原體,又不影響細胞本身的代謝,而且處理過的細胞不會重新感染支原體。另外,配合支原體檢測試劑盒可以幫助儘快發現支原體的污染。
支原體污染後果
細胞株若受到細菌、真菌、支原體、或是特定病毒等之污染時,會嚴重的影響實驗的結果。而細菌、真菌等之微生物污染時,較易自培養基等的外觀變化察覺。但是若受到支原體之污染時,細胞之外觀較無明顯變化,但是其污染會造成細胞之生長速率緩慢、細胞產生病變之型態改變等等變化。
高污染率的原因
1、支原體size 0.1~0.8 um,無細胞壁,可透過一般過濾膜(0.22-0.45 um)
2、支原體污染時,沒有明顯的肉眼或一般光學顯微鏡可觀察到的特徵變化
3、過去缺乏簡單、快速且可靠的檢測方式
4、細胞流通間缺乏品管,造成實驗室間的相互污染
5、研究或操作人員忽略污染問題
去除支原體污染
1、抗生素處理:BM-cyclin(Roche),MRA(mycoplasma removal agent,ICN),Ciprofloxcin(Bayer),Enrofloxacin(Bayer)
2、Nucleic acid metabolites:5-bromouracil,Hoechst 33258,bromodeoxyuridine
3、Anti-sera
預防與控制方面
設備方面:
1、使用已作支原體測試ok之細胞株
2、於另一隔離之區域操作未知是否有支原體污染之細胞
3、使用不添加抗生素的培養基培養細胞
檢測方面:定期以標準的支原體檢測方法檢測細胞、培養基、血清、ddH2O有否被支原體污染。
實驗操作人員之無菌觀念與無菌操作技術之要求
支原體污染問題
1、應如何避免細胞污染?
細胞污染的種類可分成細菌、酵母菌、黴菌、病毒和支原體。主要的污染原因為無菌操作技術不當、操作室環境不佳、污染之血清和污染之細胞等。嚴格之無菌操作技術、清潔的環境、與品質良好之細胞來源和培養基配製是減低污染之最好方法。
2、如果細胞發生微生物污染時,應如何處理?
直接滅菌後丟棄之。
3、支原體(mycoplasma) 污染的細胞,是否能以肉眼觀察出異狀?
不能。除極有經驗之專家外,大多數遭受支原體污染的細胞株,無法以其外觀分辨之。
4、支原體污染會對細胞培養有何影響?
支原體污染幾乎可影響所有細胞之生長參數,代謝及研究之任一數據。故進行實驗前,必須確認細胞為mycoplasma-free,實驗結果之數據方有意義。
5、偵測出細胞株有支原體污染時,該如何處理?
直接滅菌後丟棄,以避免污染其它細胞株。
支原體之檢測
直接培養法
原理:直接培養支原體於培養基中,觀察其生長及菌落生成。
特點:是目前最直接與靈敏之步驟,亦是用來評估其它偵測新步驟之標準步驟。
缺點:培養時間長,須3-5星期才能判斷。有些支原體不能在培養基培養出來(例如M. hyorhinis)。需同時培養支原體株作為正反應對照組,可能會造成污染。
材枓:dextrose、L-arginine HCl、Difco PPLO broth (Difco 0554-17-1) horse serum、15% yeast extract solution (autoclaved)、Bacto agar、無菌有蓋螺鏇試管(autoclaved)、無菌培養皿﹙60x15mm﹚、L-玻棒、37℃培養箱、厭氧缸(厭氧缸長期培養易有污染,所以厭氧包套用無菌水,每次打開厭氧缸後,用70% ethanol擦拭內壁。)
培養基製備:
基本配方為Difco PPLO broth(60%), 馬血清(20%), 15% yeast extreat solution (10%), 10x stock solution (10%)。由於培養時間長,可加入Penicillin(50u/ml)至10x stock solution或加入thallium acetate (1:2000)至培養基中以防止其它細菌污染。
· 10x stock solution (1 liter) :稱取50 gdextrose,10 gL-arginine HCl,溶於1 liter蒸餾水中。以0.22μm無菌過濾膜過濾滅菌。分裝100 ml至瓶中,保存於-70℃。
· 液體培養基(1 liter) :稱取21 g之Difco PPLO broth,0.02 gphenol red 於600ml蒸餾水中,加熱攪拌溶解之。滅菌121℃,15分鐘。待溫度降低至室溫後,於無菌操作台內加入200ml馬血清,100ml之15% yeast extract solution,及100ml解涷之10x stock solution,混合均勻後,分裝至已滅菌之有蓋螺鏇試管中,10ml/管。保存於4℃,期限1個月。
· 固體培養基(1 liter ):稱取21 g之Difco PPLO broth,0.02 gphenol red,15gBacto agar於600ml蒸餾水中,加熱溶解之。滅菌121℃,15分鐘。放在50℃水中浴中,待溫度降低至50℃時,於無菌操作台內加入200ml馬血清,100ml之15% yeast extract solution 及100ml解凍之10x stock solution,混合均勻後,倒入60x50㎜之無菌培養皿中,5ml/培養皿。保存於4℃,期限1個月。
步驟:
· 取1 ml細胞培養液或0.2ml細胞懸浮液,接種於液體培養基中,置於37℃培養二周,觀察是否有混濁或是pH值改變之情形。培養一周及二周后,分別取0.1 ml液體培養液塗在agar plate上,將其倒放置於37℃厭氧箱培養,培養至少3星期,持續觀察是否有支原體之菌落出現。
· 另取1 ml細胞培養液或0.2ml細胞懸浮液,塗抹在agar plate上,37℃厭氧培養3星期,持續觀察是否支原體菌落出現。
· 另作正負反應對照組,正反應對照組為Acholeplasma laidlawii (ATCC 23206) 與M. arginini (ATCC 23838)。負反應對照組為待測細胞之新鮮培養基。
結果判讀:
· 支原體生長較慢,所以先在液體培養基培養1~2周增殖後,再培養於agar plate上。需至少培養3星期後,才可斷定是否有支原體污染。所以整個測試需5個星期才知正確結果。
· 典型之支原體菌落類似荷包蛋(fried- egg like),乃是由於支原體往agar下層生長所致,為圓形無色透明菌落,大小約10-55μm。但是並非所有的支原體皆為似荷包蛋菌落,有些是圓形菌落或是類似粘菌類形態(slime)。
· 若要區分細胞或是氣泡造成的類似菌落,可將其自agar plate上切下,重新培養於液體培養基中,培養一星期後再種入agar plate,若是細胞則不會生長。

